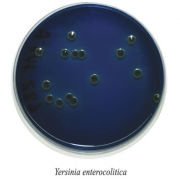
Иерсения-агар
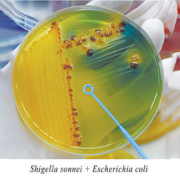
Лактозный ТТХ агар с тергитолом 7

Каталог товаров
Фильтр
Цена
Другие фильтры
Производитель
Стерильность
Форма выпуска
Документы
Сокращенный рабочий день 26.06.2026
26 Июня 2026, Пт
Обращаем ваше внимание, что в связи с проведением корпоративного мероприятия 26 июня 2026 года (пятница) объявлен сокращенным рабочим днем.
С Днем медицинского работника
21 Июня 2026, Вс
ГК «ПанЭко» поздравляет тех, кто помогает сохранить здоровье людей и обеспечивает развитие медицинской науки.
ГК «ПанЭко» поздравляет с Днем России!
10 Июня 2026, Ср
Группа компаний «ПанЭко» поздравляет вас с Днем России!
ГК «ПанЭко» приняла участие в юбилейной конференции ВИЛАР
05 Июня 2026, Пт
ГК «ПанЭко» приняла участие в юбилейной конференции ВИЛАР, посвященной 95-летию института.